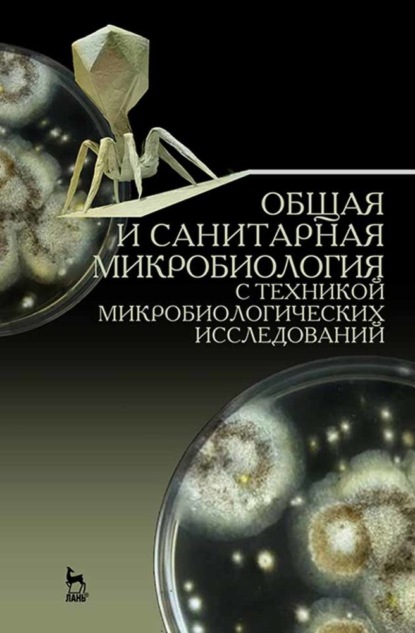
Скачать книгу Общая и санитарная микробиология с техникой микробиологических исследований

Общая и санитарная микробиология с техникой микробиологических исследований
Полная версия
В пособии освещены вопросы общей и санитарной микробиологии. Описаны требования по технике безопасности, методы дезинфекции и стерилизации, манипуляции с экспериментальными животными. Дана информация об оснащении бактериологической лаборатории и методах микробиологии, технике выращивания и изучения микроорганизмов в живом и окрашенном состоянии, приготовлении питательных сред, изучении антибиотикоустойчивости, дифференциально-диагностическом тестировании. Включен материал по бактериофагам, генетике бактерий, идентификации микроорганизмов с помощью ПЦР, об иммунитете и методах его оценки. Особое место занимают главы о физиолого-биохимических свойствах микроорганизмов и современных технологиях, применяемых в клинической микробиологии. Рассмотрены основные задачи и методы санитарно-микробиологических исследований воды, почвы, воздуха, пищевых продуктов, перевязочных средств и т. д. Для учащихся медицинских училищ, колледжей.
- О книге